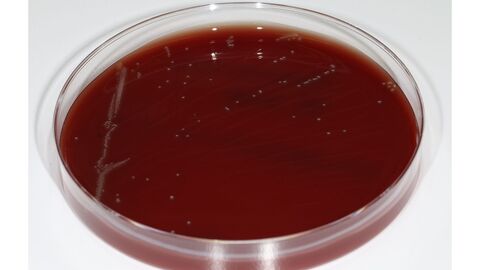
Blutagarplatte Erysipelothrix anatis
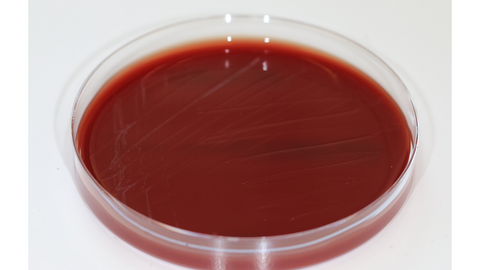
Blutagarplatte Erysipelothrix anatis

Die Fälle
Wir berichten über die Beschreibung von drei neuen Bakterienspezies aus der Gattung des Rotlauferreger Erysipelothrix. Die neuen Arten wurden in unseren sowie in weiteren Laboren unserer Kooperationspartner isoliert und aufgrund herausstechender Unterschiede zunächst nur als zur Gattung Erysipelothrix zugehörig eingestuft. Weitere umfangreiche Untersuchungen durch unser Netzwerk an Partnern bestätigten schließlich deren Eigenständigkeit als neue Spezies.
Die Gattung Erysipelothrix und der Rotlauferreger E. rhusiopathiae |
|
Erysipelothrix (E.) rhusiopathiae kommt weltweit vor. Man findet diesen Erreger auch in Umweltproben, von wo sich viele Tierarten damit infizieren könnenÖffnet sich in einem neuen Fenster. Bei Schweinen ist Rotlauf eine schon lange bekannte, wirtschaftlich bedeutsame und mit einer Beeinträchtigung des Tierwohls einhergehende Infektionskrankheit, die sich u.a. durch eine Rotverfärbung der Haut manifestiert, daher der Name. Allerdings kann Rotlauf bei Schweinen auch zu einer Herzentzündung führen. Der Rotlauferreger ist zudem ein bekannter Infektionserreger beim Menschen, wobei eine Übertragung vom Tier auf den Menschen die größte Bedeutung hat (Zoonose). Bekannt sind lokale (sog. Erysipeloid) oder sich ausbreitende Hautinfektionen und Herzklappenentzündungen (Endokarditis) als Folge einer Bakteriämie. Rotlaufinfektionen beim Menschen lassen sich mit Antibiotika gut behandeln. Schweine können mit einer Impfung vor einer Infektion geschützt werden. Rotlauf-Bakterien kommen aber auch bei einer Vielzahl weiterer Tierarten vor, darunter verschiedene Arten des Geflügels, Fische, Meeressäuger u.v.a. Neben E. rhusiopathiae beinhaltete die Gattung bislang noch vier weitere Spezies: E. tonsillarum wurde ebenfalls von gesunden Schweinen beschrieben, in der Zwischenzeit jedoch auch mit Herzerkrankungen bei Hunden assoziiert. Während E. inopinata bislang nur aus einer Nährbouillon isoliert wurde, konnte man E. larvae im Darminhalt des Nashornkäfers finden. Die bislang letzte beschriebene Spezies war E. piscisicarius, welche zunächst bei Fischen, inzwischen aber – wie E. rhusiopathiae – auch bei Schweinen und Geflügel zu Erkrankungen führte. |